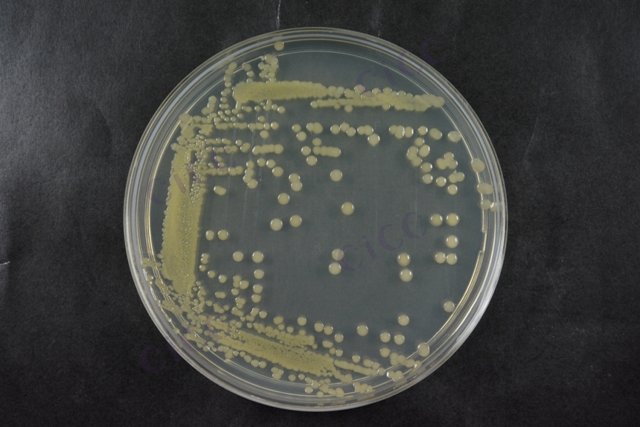
巨大芽胞杆菌 Bacillus megaterium CICC 23035 Bacillus megaterium

巨大芽胞杆菌 Bacillus megaterium CICC 23035 Bacillus megaterium
-
巨大芽胞杆菌 Bacillus megaterium CICC 10024 Bacillus megaterium
CICC 10024 | 见证书
-
巨大芽胞杆菌 Bacillus megaterium CICC 10044 Bacillus megaterium
CICC 10044 | 见证书
-
巨大芽胞杆菌 Bacillus megaterium CICC 10055 Bacillus megaterium
CICC 10055 | 见证书
-
巨大芽胞杆菌 Bacillus megaterium CICC 10324 Bacillus megaterium
CICC 10324 | 见证书
-
巨大芽胞杆菌 Bacillus megaterium CICC 10329 Bacillus megaterium
CICC 10329 | 见证书
-
巨大芽胞杆菌 Bacillus megaterium CICC 10448 Bacillus megaterium
CICC 10448 | 见证书
-
巨大芽孢杆菌 Bacillus megaterium
BNCC190686 | 冻干粉;斜面;菌液;平板

说明书下载: 菌种说明书 打管说明书
您正在浏览的产品:巨大芽胞杆菌 Bacillus megaterium CICC 23035
手机版:巨大芽胞杆菌 Bacillus megaterium CICC 23035
本公司销售的所有产品仅供实验科研使用,不用于人体及临床诊断。
1. 形态学观察(革兰氏染色、芽孢形成能力);
2. 生理生化试验(接触酶、V-P反应等);
3. 分子生物学鉴定(16S rDNA序列分析)。
1. 阳性对照(标准菌株);
2. 阴性对照(无菌培养基);
3. 平行样品重复检测(≥3次)。
2. 选择性培养基培养(37℃, 24-48h);
3. 菌落特征验证(形态、生化反应);
4. 芽孢染色确认。
2. 环境样品检测时需评估杂菌抑制方法;
3. 功能验证(如解磷能力)需结合应用场景设计附加实验。
以上信息仅供参考,请以相应标准的原文为准!